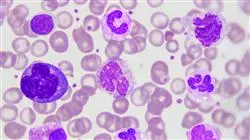
##IMAGE##

Titolo universitario
La più grande facoltà di medicina del mondo"
Presentazioni
Approfondisci gli ultimi sviluppi in materia di Anemia con una Master class tenuta da un referente mondiale nel campo dell'ematologia"

La specialità dell'ematologia è attualmente pioniera nell'innovazione nei settori della diagnosi e del trattamento, e va notato che gli ematologi sono all'avanguardia nell'applicazione clinica dell'immunoterapia nella lotta contro diversi tumori ematologici.
Le varie società scientifiche di questa specialità in tutto il mondo si sforzano di incorporare rapidamente i risultati della ricerca biomedica nella pratica clinica, in particolare il trattamento delle emopatie maligne (tumori ematologici), così come la carenza di ferro e le anemie, la somministrazione di Anticoagulanti Orali ad Azione Diretta (DOAC), i trapianti di midollo osseo e, a lungo termine, la ricerca focalizzata sulla produzione di sangue artificiale con l'obiettivo finale di garantire che i dirigenti sanitari includano quanto prima queste tecniche nei servizi dei sistemi sanitari.
Le ragioni per cui l'ematologia e l'emoterapia sono discipline mediche che hanno fatto più progressi in termini di conoscenza e tecnologia negli ultimi decenni risiedono nell'integrazione delle conoscenze biologiche e cliniche, che hanno portato a una migliore comprensione dei meccanismi della malattia, facilitando lo sviluppo di linee guida di azione clinica più appropriate. Tutto questo ha contribuito al fatto che ematologia ed emoterapia abbiano raggiunto un notevole grado di maturità e giustifica la loro permanenza nel futuro come specialità integrate, essendo questo il quadro ideale per la preparazione e il miglioramento globale degli specialisti in questa area di competenza medica.
Questo Corso universitarioin Aggiornamento sull'Anemia supporta gli ultimi progressi della ricerca e le più alte evidenze scientifiche, con un programma di insegnamento solido e didattico che lo posiziona come un titoli di altissima qualità scientifica a livello internazionale. Include anche una Master class tenuta da un leader mondiale nel campo dell'ematologia, arricchendo ulteriormente il contenuto. Questo programma è rivolto agli operatori sanitari che, nella loro pratica clinica quotidiana, affrontano l'attenzione di pazienti o categorie con malattie emorragiche. Il programma educativo è supportato da un approccio multidisciplinare alle sue materie, consentendo una formazione e miglioramento professionale in diversi settori.
Con questo Corso universitario in Aggiornamento sull'Anemia hai l'opportunità di aggiornare comodamente le tue conoscenze senza rinunciare al massimo rigore scientifico”
Questo Corso universitario in Aggiornamento sull'Anemia possiede il programma scientifico più completo e aggiornato del mercato. Le caratteristiche principali del programma sono:
- Sviluppo di casi clinici presentati da esperti in ematologia
- Contenuti grafici, schematici ed eminentemente pratici che forniscono informazioni scientifiche e pratiche riguardo alle discipline mediche essenziali per l’esercizio professionale
- Novità diagnostico-terapeutiche sulla valutazione, diagnosi e intervento nel paziente ematologico
- Esercizi pratici che offrono un processo di autovalutazione per migliorare l'apprendimento
- Iconografia clinica e di test di imaging per uso diagnostico
- Sistema di apprendimento interattivo basato su algoritmi per il processo decisionale in scenari clinici
- Speciale enfasi sulla medicina basata sull’evidenza e le metodologie di ricerca in ematologia
- Lezioni teoriche, domande all'esperto, forum di discussione su questioni controverse e lavoro di riflessione individuale
- Contenuti disponibili da qualsiasi dispositivo fisso o mobile dotato di connessione a internet
Questo Corso universitario è il miglior investimento che tu possa fare per conoscere le ultime novità riguardanti l’Aggiornamento sull’Anemia”
Il programma include nel suo personale docente professionisti del settore che condividono la loro esperienza di lavoro in questa formazione, oltre a rinomati specialisti di società di riferimento e università di prestigio.
I contenuti multimediali, sviluppati in base alle ultime tecnologie educative, forniranno al professionista un apprendimento coinvolgente e localizzato, ovvero inserito in un contesto reale.
La creazione di questo programma è incentrata sull’Apprendimento Basato su Problemi, mediante il quale il professionista deve cercare di risolvere le diverse situazioni che gli si presentano durante il corso. A tal fine, potrai contare su un innovativo sistema video interattivo realizzato da esperti riconosciuti.
Il Corso universitario permette di fare pratica in ambienti simulati, che forniscono un apprendimento coinvolgente programmato per la formazione di fronte a situazioni reali"
Include casi clinici per portare lo sviluppo del programma il più vicino possibile alla realtà dell'assistenza medica"
Perché studiare al TECH?
TECH è la più grande università digitale del mondo. Con un catalogo eccezionale di oltre 14.000 programmi accademici disponibili in 11 lingue, si posiziona come leader in termini di occupabilità, con un tasso di inserimento professionale del 99%. Inoltre, dispone di un enorme personale docente, composto da oltre 6.000 professori di altissimo prestigio internazionale.

Studia presso la più grande università digitale del mondo e assicurati il successo professionale. Il futuro inizia con TECH”
La migliore università online al mondo secondo FORBES
La prestigiosa rivista Forbes, specializzata in affari e finanza, ha definito TECH «la migliore università online del mondo». Lo hanno recentemente fatto notare in un articolo della loro edizione digitale che riporta il caso di successo di questa istituzione, «grazie all'offerta accademica, alla selezione del suo personale docente e a un metodo di apprendimento innovativo orientato alla formazione dei professionisti del futuro».
Un metodo di studio dirompente, un personale docente all'avanguardia e il suo orientamento pratico: elementi chiave del successo di TECH.
I piani di studio più completi del panorama universitario
TECH offre i piani di studio più completi del panorama universitario, con argomenti che coprono concetti fondamentali e, allo stesso tempo, i principali progressi scientifici nelle loro specifiche aree scientifiche. Inoltre, questi programmi sono continuamente aggiornati per garantire agli studenti l'avanguardia accademica e le competenze professionali più richieste. In questo modo, i titoli universitari forniscono agli studenti un vantaggio significativo per elevare le loro carriere verso il successo.
TECH dispone dei piani di studio più completi e intensivi del panorama universitario attuale.
Il miglior personale docente internazionale top
Il personale docente di TECH è composto da oltre 6.000 docenti di massimo prestigio internazionale. Professori, ricercatori e dirigenti di multinazionali, tra cui Isaiah Covington, allenatore dei Boston Celtics; Magda Romanska, ricercatrice principale presso MetaLAB ad Harvard; Ignacio Wistumba, presidente del dipartimento di patologia molecolare traslazionale di MD Anderson Cancer Center; o D.W Pine, direttore creativo della rivista TIME, ecc.
Esperti di livello internazionale, specializzati in diversi settori in materia di Salute, Tecnologia, Comunicazione e Business, fanno parte del personale docente di TECH.
Un metodo di apprendimento unico
TECH è la prima università ad utilizzare il Relearning in tutte le sue qualifiche. Si tratta della migliore metodologia di apprendimento online, accreditata con certificazioni internazionali di qualità docente, disposte da agenzie educative prestigiose. Inoltre, questo modello accademico dirompente è integrato con il "Metodo Casistico", configurando così una strategia di insegnamento online unica. Vengono inoltre implementate risorse didattiche innovative tra cui video dettagliati, infografiche e riassunti interattivi.
TECH combina il Relearning e il Metodo Casistico in tutti i suoi programmi universitari per garantire un apprendimento teorico-pratico di eccellenza studiando quando e da dove vuoi.
La più grande università digitale del mondo
TECH è la più grande università digitale del mondo. Siamo la più grande istituzione educativa, con il migliore e più ampio catalogo educativo digitale, cento per cento online e che copre la maggior parte delle aree di conoscenza. Offriamo il maggior numero di titoli di studio, diplomi e corsi post-laurea nel mondo. In totale, più di 14.000 corsi universitari, in undici lingue diverse, che ci rendono la più grande istituzione educativa del mondo.
TECH possiede il più ampio catalogo di programmi accademici e ufficiali al mondo, disponibile in oltre 11 lingue.
Google Partner Premier
Il gigante americano della tecnologia ha conferito a TECH il logo Google Partner Premier. Questo premio, accessibile solo al 3% delle aziende del mondo, conferisce valore all'esperienza efficace, flessibile e adattata che questa università offre agli studenti. Il riconoscimento non solo attesta il massimo rigore, rendimento e investimento nelle infrastrutture digitali di TECH, ma fa anche di questa università una delle compagnie tecnologiche più all'avanguardia del mondo.
Google ha posizionato TECH tra il 3% delle più importanti aziende tecnologiche del mondo, conferendogli il suo loro Google Partner Premier.
L’università online ufficiale dell’NBA
TECH è l'università online ufficiale dell'NBA. Grazie ad un accordo con la più grande lega di basket, offre ai suoi studenti programmi universitari esclusivi, nonché una vasta gamma di risorse educative incentrate sul business della lega e su altre aree dell'industria sportiva. Ogni programma ha un piano di studi di design unico e presenta relatori ospiti eccezionali: professionisti con una distinta carriera sportiva che offriranno la loro esperienza nelle materie più rilevanti.
TECH è stata riconosciuta dall'NBA, la più importante lega di basket del mondo, come sua università online ufficiale.
L'università meglio valutata dai suoi studenti
Il sito di valutazione Global score ha posizionato TECH come l'università più apprezzata al mondo dai suoi studenti. Questo portale di recensioni, il più affidabile e prestigioso perché verifica e convalida l'autenticità di ogni opinione pubblicata, ha assegnato a TECH la sua valutazione più alta, 4,9 su 5, sulla base di oltre 1.000 recensioni ricevute. Cifre che rendono TECH un riferimento universitario assoluto a livello internazionale.
TECH è l'università meglio valutata al mondo dai suoi studenti.
Leader nell'occupabilità
TECH è riuscita a diventare l'università leader nell'occupabilità. Il 99% dei suoi studenti ottiene un lavoro nel campo accademico che hanno studiato, prima di completare un anno dopo aver terminato uno qualsiasi dei programmi universitari. Una cifra simile riesce a migliorare la propria carriera professionale immediatamente. Tutto questo grazie ad una metodologia di studio che basa la sua efficacia sull'acquisizione di competenze pratiche, assolutamente necessarie per lo sviluppo professionale.
Il 99% degli studenti di TECH ottiene il lavoro a cui aspira nel primo anno dopo aver completato gli studi.
Corso Universitario in Aggiornamento sull'Anemia
Il frequente coinvolgimento dei casi di anemia nella popolazione generale ha portato i processi diagnostici e terapeutici di fronte a questa classe di patologie a distinguersi come uno dei campi medici di maggiore occupabilità oggi, i servizi richiesti presso strutture sanitarie di vario tipo. A causa di questa situazione, i professionisti specializzati in materia godono oggi di un ampio campo di opportunità di lavoro diverse. Comprendendo la crescente necessità di aggiornamento accademico che accompagna il crescente interesse per l'accesso a questa importante nicchia occupazionale, a TECH Global University abbiamo preparato il nostro Corso Universitario in Aggiornamento sull'Anemia. Questo post-laurea approfondirà le nuove alternative di trattamento utilizzate nella gestione di pazienti con anemie prodotte da disturbi dell'emoglobina. Si approfondirà inoltre la modernizzazione dei seguenti aspetti: l'individuazione delle sfide diagnostiche nel l'individuazione delle anemie emolitiche; e la conoscenza dei diversi trattamenti attualmente implementati nella cura dei casi di anemia diseritropoyetica congenita.
Studia un Corso Universitario online sull'aggiornamento sulle anemie
La grande diversità dei metodi diagnostici, analitici e terapeutici applicati nel campo dell'attenzione ai casi di anemia evidenzia questa specialità come uno dei campi più esigenti per quanto riguarda il grado di conoscenza e preparazione dei suoi professionisti. Nel nostro programma affronterai la gestione dei nuovi strumenti e metodologie implementate nel settore, contemplando le tendenze protocollari che segnano lo sviluppo futuro dell'area. Inoltre, in questo corso di laurea si approfondirà l'aggiornamento del professionista sulle seguenti tematiche: la conoscenza dei più recenti progressi nel trattamento applicato a pazienti con anemia megaloblastica; seguito dalle particolarità da prendere in considerazione nello sviluppo dei processi diagnostici applicati al rilevamento di casi di anemia ferropenica.







